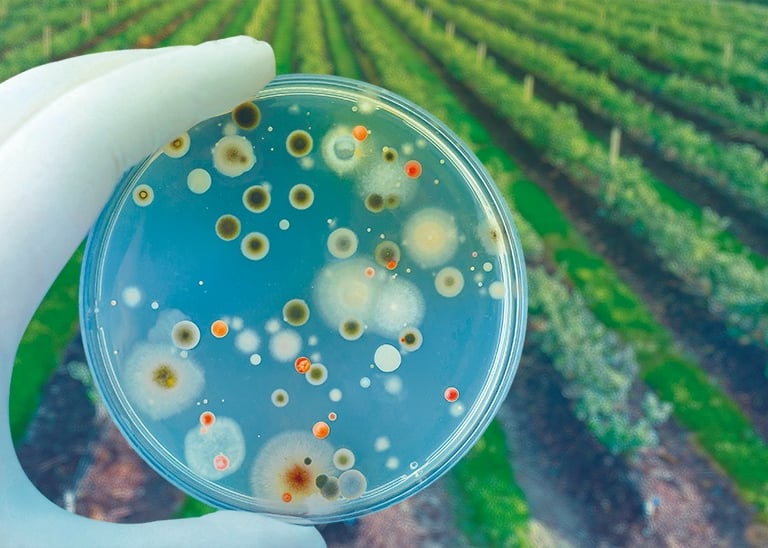
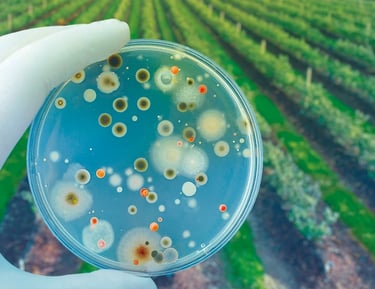

¿Cuánto perdés por no conocer
la biología de tu suelo?
Más del 20% de los suelos de Córdoba están biológicamente degradados — y la mayoría de los productores no lo saben hasta que el rinde cae
Tomás decisiones sin conocer la biología de tu suelo
La mayoría de los análisis agronómicos se enfocan en la química.
Pero el suelo es un ecosistema vivo, y sin medir su biología, estás trabajando con la mitad de la información.
Tomá decisiones con datos reales
Sin microbiología, fertilizas a ciega
Recuperá la salud de tu suelo
Medí lo que otros análisis no ven.
NUESTRA HISTORIA
Microlab nació con un propósito claro: llevar el análisis microbiológico al centro de la toma de decisiones agronómicas.
Somos un laboratorio especializado en biología de suelo, agua y bioinsumos, ubicado en Villa Nueva, Córdoba.




Somos socios estratégicos de Laboratorio Análisis Agropecuarios, sumando capacidad química y física a nuestra especialidad microbiológica.
"Trabajamos bajo criterios técnicos alineados a estándares nacionales. Cada informe es revisado y validado personalmente por la Dra. Laura Boiero. Tu análisis no es un trámite — es un diagnóstico."
★★★★★
Nuestro valor
Nuestros servicios
Análisis microbiológicos con informes claros, recomendaciones prácticas y acompañamiento experto.
Biológico de suelo y compost

Microbiológico de agua
Para comprobar la efectividad y seguridad de los bioinsumos agrícolas, siguiendo protocolos de “REDCAI”.
Control de calidad de Inoculantes
Desarrollo de estudios específicos para clientes, soluciones a medidas, seguimiento de resultados específicos. Charlas, y capacitación.
Consultoría y Capacitación


Control higénico ambiental
Análisis sanitario de semillas
Mediante Blotter test, es una decisión clave antes de implantar, para reducir riesgos de fallas de germinación y diseminación de enfermedades.
Determinar si es apta para consumo, y cumple con las normativas requeridas para su consumo y uso en la industria y el hogar.
Conocer la diversidad de suelos y compost, permitirán diseñar un plan de manejo, optimizando recursos y garantizando la sostenibiliddad.


Evaluar el estado sanitario de superficies, equipamiento, ropa y manos del personal en industrias, o establecimientos productores.


"Sin datos reales, no hay decisiones correctas. Sin decisiones correctas, no hay productividad sostenible."
SOBRE MI
Dra. en Ciencias Químicas
FUNDADORA & CEO
Fundadora de Microlab
Microbióloga
Especializada en Microbiología
La microbióloga detrás de cada análisis
Especialista en alimentos y aplicaciones agrícola
Alianza con Lab. Análisis Agropecuarios
Dra. Laura Boiero
Empezar es más simple de lo que pensás
En 3 pasos tenés tu diagnóstico microbiológico completo
Agendá tu llamada de claridad
Gratuita · 20 minutos
Contanos tu sistema productivo y qué querés medir. Sin compromiso, sin tecnicismos. Solo una conversación enfocada en tu campo.
Tomamos o coordinamos tu muestra Simple · Sin interrumpir
Te guiamos paso a paso para tomar la muestra correctamente, o coordinamos el retiro según tu zona.
Recibís tu informe interpretado · No solo números — decisiones concretas
En días tenés tu informe con semáforos de alerta, interpretación técnica y recomendaciones accionables para tu próxima campaña.


03
01
02
Cada campaña sin datos microbiológicos es productividad que dejás en el campo
La llamada de claridad es gratuita, dura 20 minutos y te da un diagnóstico inicial de qué medir en tu suelo
Sin costo ni compromiso
20 minutos enfocados en tu campo
Diagnóstico inicial personalizado
Sabés exactamente qué análisis necesitás
Atención directa con la Dra. Laura Boiero
Resultado accionable desde el primer día
Aplicable a cualquier sistema productivo
Cupos limitados por semana
Contacto
¿Listo para conocer la biología de tu suelo?
servicios@microlabagri.com
Teléfono
353-4146733
Dirección
25 de Mayo 7, Villa Nueva.
Córdoba, Argentina.




